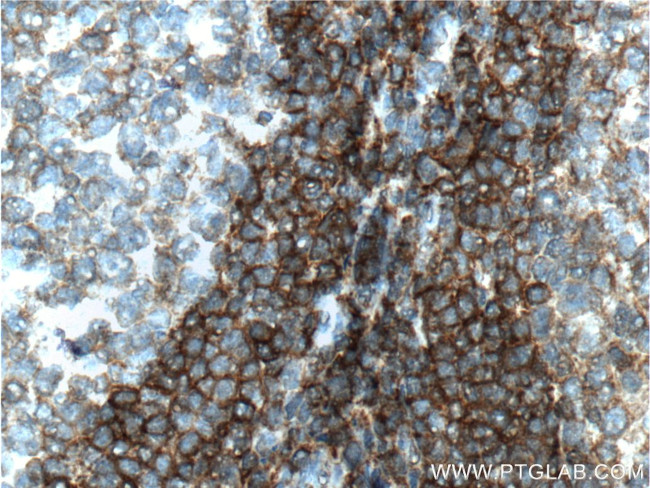
TNFRSF13C Antibody in Immunohistochemistry (Paraffin) (IHC (P))

Search
Proteintech
TNFRSF13C Polyclonal Antibody
{{$productOrderCtrl.translations['antibody.pdp.commerceCard.promotion.promotions']}}
{{$productOrderCtrl.translations['antibody.pdp.commerceCard.promotion.viewpromo']}}
{{$productOrderCtrl.translations['antibody.pdp.commerceCard.promotion.promocode']}}: {{promo.promoCode}} {{promo.promoTitle}} {{promo.promoDescription}}. {{$productOrderCtrl.translations['antibody.pdp.commerceCard.promotion.learnmore']}}
产品信息
22582-1-AP
种属反应
宿主/亚型
分类
类型
抗原
偶联物
形式
浓度
规格
纯化类型
保存液
内含物
保存条件
运输条件
产品详细信息
Immunogen sequence: MRRGPRSLR GRDAPAPTPC VPAECFDLLV RHCVACGLLR TPRPKPAGAS SPAPRTALQP QESVGAGAGE AALPLPGLLF GAPALLGLAL VLALVLVGLV SWRRRQRRLR GASSAEAPDG DKDAPEPLDK VIILSPGISD ATAPAWPPPG EDPGTTPPGH SVPVPATELG STELVTTKTA GPEQQ (1-184 aa encoded by BC105123)
靶标信息
Tumor necrosis factor receptor superfamily member 13C (TNFRSF13C), also known as BAFFR, is a protein in humans is encoded by the TNFRSF13C gene. The BAFFR gene is mapped to chromosome 22q13. 1-q13. 31. It has got 184 amino acid transmembrane protein which is 56% identical to the mouse protein. B cell-activating factor (BAFF) enhances B-cell survival in vitro and is a regulator of the peripheral B-cell population. BAFF plays a crucial role in B cell development and can function through receptors other than BCMA.
仅用于科研。不用于诊断过程。未经明确授权不得转售。
篇参考文献 (0)
生物信息学
蛋白别名: B cell-activating factor receptor; B-cell-activating factor receptor; BAFF receptor; BAFF-R; BLyS receptor 3; CD268; Tumor necrosis factor receptor superfamily member 13C
基因别名: BAFF-R; BAFFR; BR3; BROMIX; CD268; CVID4; prolixin; TNFRSF13C
UniProt ID: (Human) Q96RJ3
Entrez Gene ID: (Human) 115650